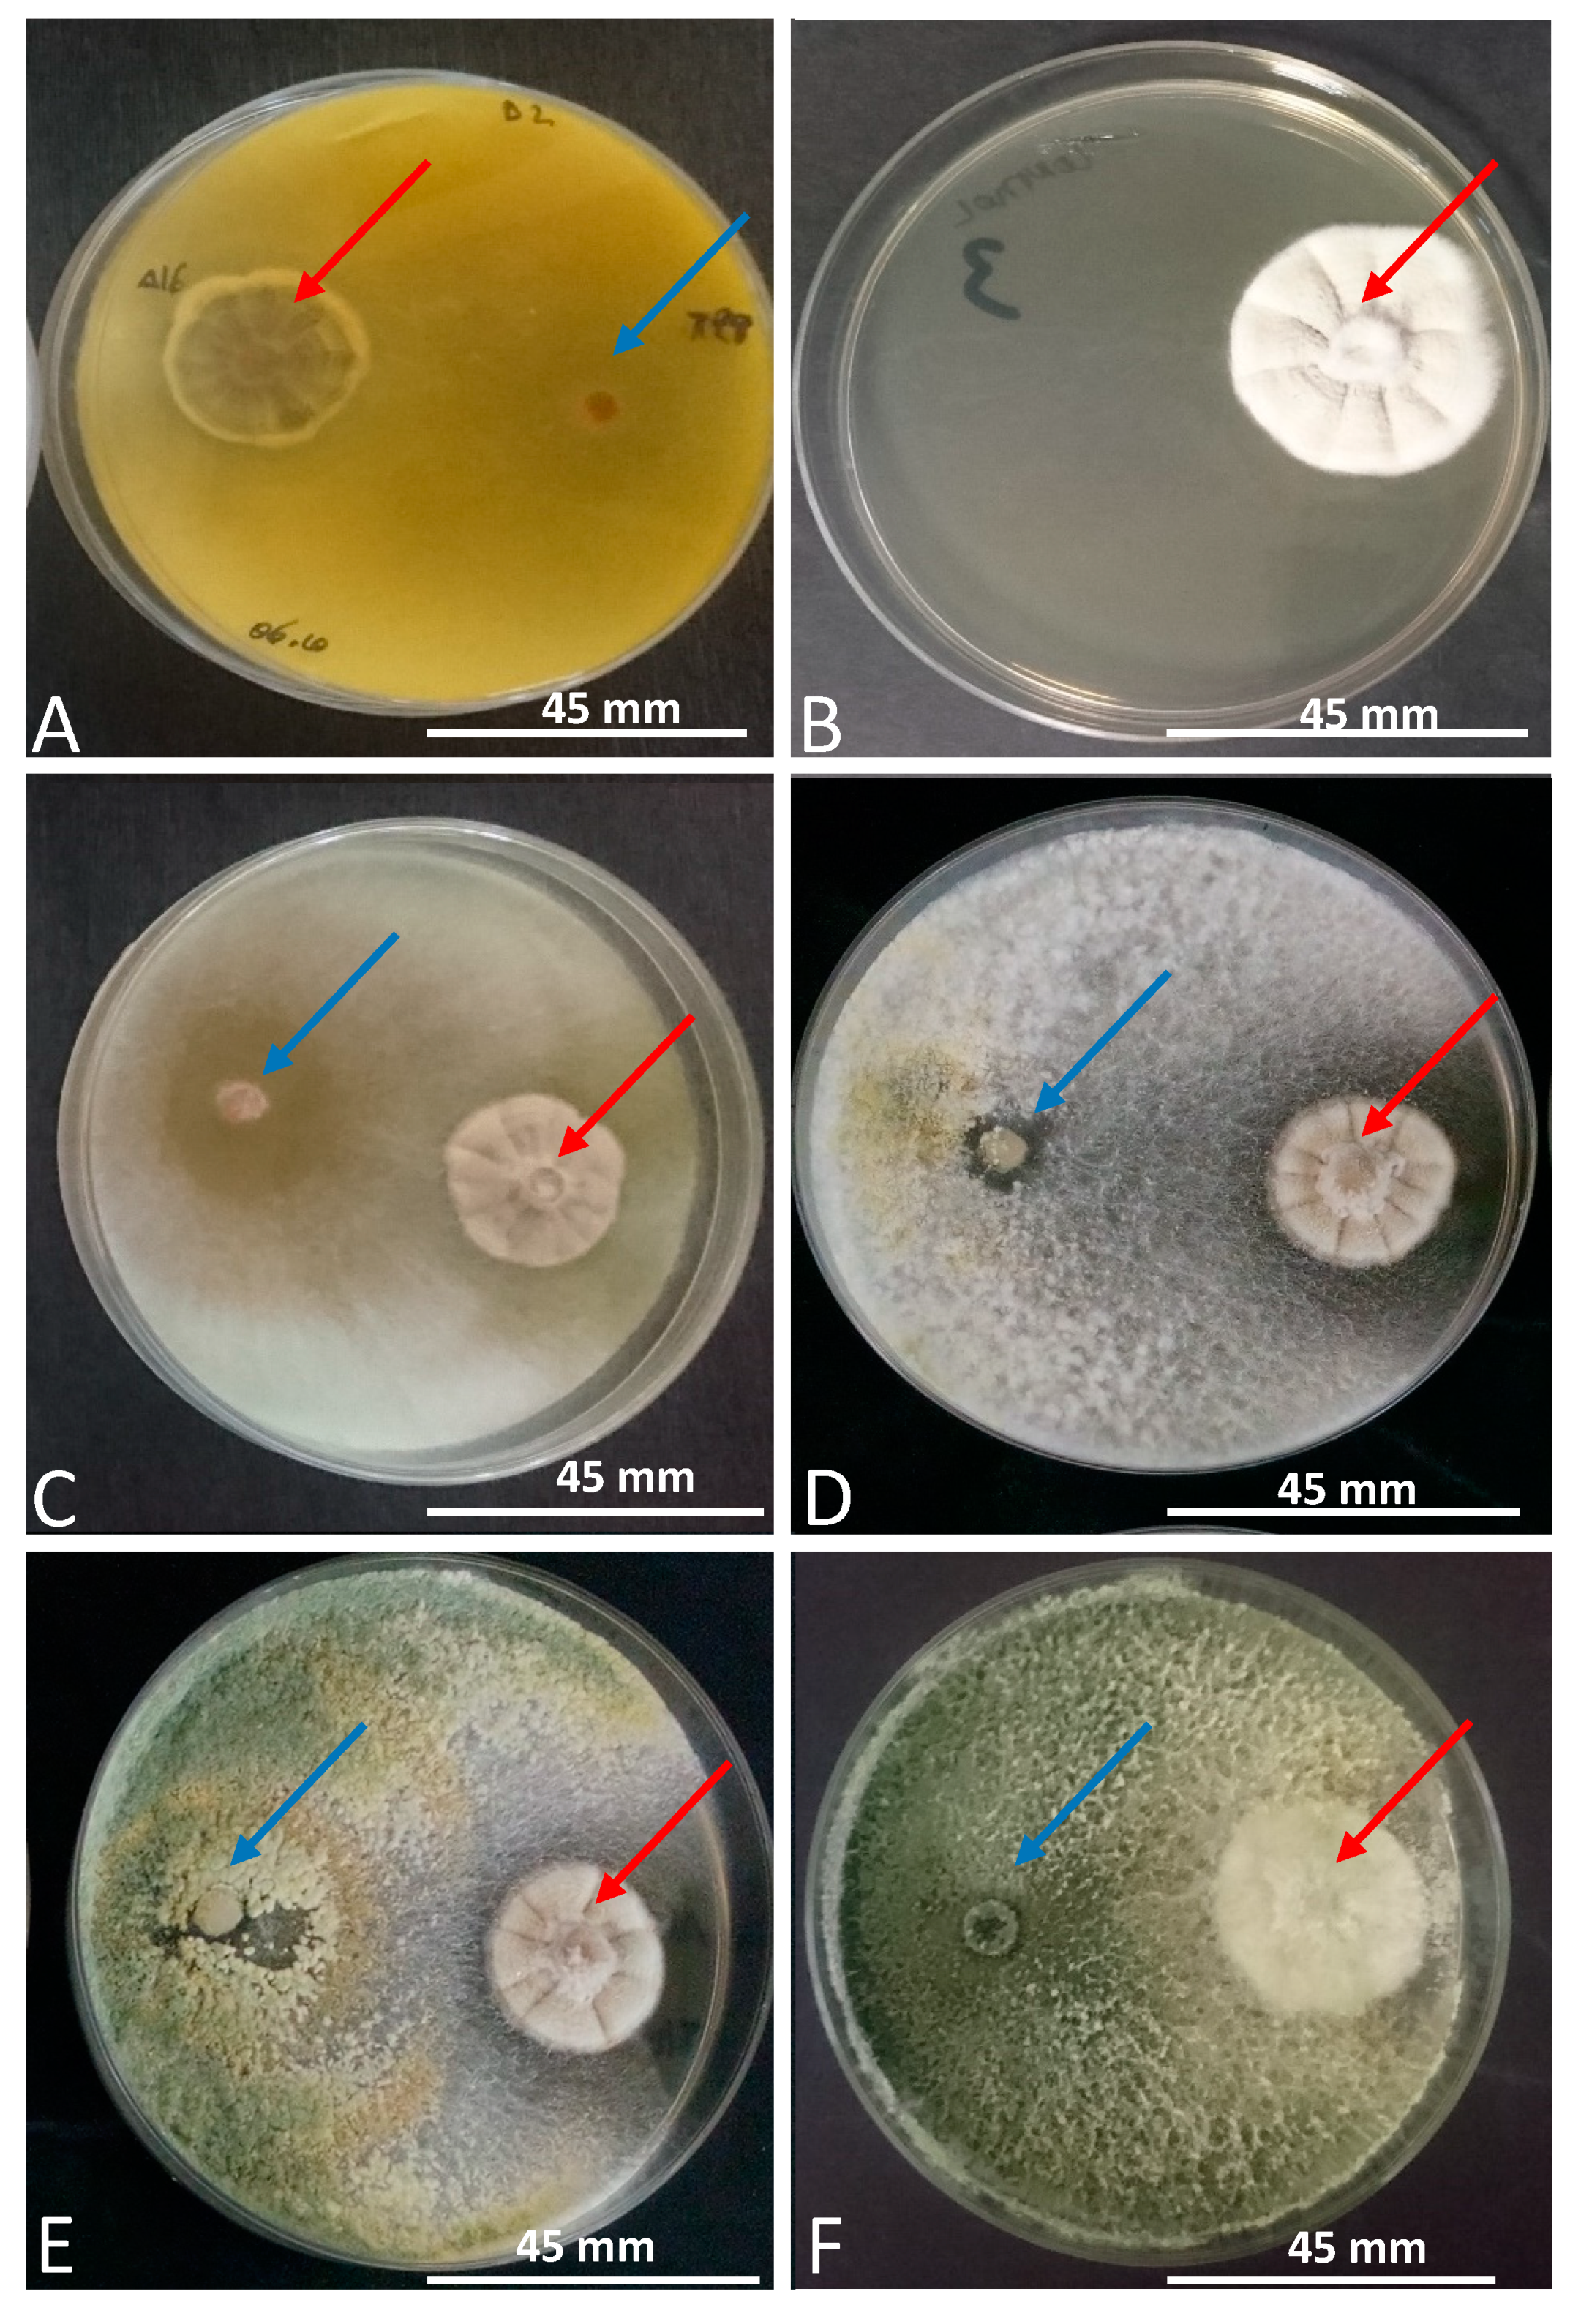

Influence of Fungicide Application and Vine Age on Trichoderma Diversity as Source of Biological Control Agents
Abstract
1. Introduction
2. Materials and Methods
2.1. Location and Vine Age
2.2. Fungicide Treatment and Vine Age
2.3. Sample Processing, Trichoderma Isolation and Quantification
2.4. DNA Extraction, PCR Amplification, and Sequencing
2.5. Biocontrol Assays
Statistical Analysis
2.6. Identification of Parameters Involved in Trichoderma spp. Diversity
3. Results
3.1. Trichoderma Isolation, Quantification and Identification
3.2. Biocontrol Assays
3.3. Identification of Parameters Involved in Trichoderma spp. Diversity
4. Discussion
5. Conclusions
Author Contributions
Funding
Institutional Review Board Statement
Informed Consent Statement
Data Availability Statement
Acknowledgments
Conflicts of Interest
References
- Druzhinina, I.S.; Seidl-Seiboth, V.; Herrera-Estrella, A.; Horwitz, B.A.; Kenerley, C.M.; Monte, E.; Mukherjee, P.K.; Zeilinger, S.; Grigoriev, I.V.; Kubicek, C.P. Trichoderma: The genomics of opportunistic success. Nat. Rev. Microbiol. 2011, 9, 749–759. [Google Scholar] [CrossRef] [PubMed]
- Vinale, F.; Sivasithamparam, K.; Ghisalberti, E.L.; Marra, R.; Woo, S.L.; Lorito, M. Trichoderma-plant-pathogen interactions. Soil Biol. Biochem. 2008, 40, 1–10. [Google Scholar] [CrossRef]
- Hermosa, M.; Grondona, I.; Iturriaga, E.A.; Díaz-Minguez, J.M.; Castro, C.; Monte, E.; García-Acha, I. Molecular characterization and identification of biocontrol isolates of Trichoderma spp. Appl. Environ. Microbiol. 2000, 66, 1890–1898. [Google Scholar] [CrossRef]
- Anees, M.; Tronsmo, A.; Edel-Hermann, V.; Hjeljord, L.G.; Héraud, C.; Steinberg, C. Characterization of field isolates of Trichoderma antagonistic against Rhizoctonia solani. Fungal Biol. 2010, 114, 691–701. [Google Scholar] [CrossRef] [PubMed]
- Woo, S.L.; Ruocco, M.; Vinale, F.; Nigro, M.; Marra, R.; Lombardi, N.; Pascale, A.; Lanzuise, S.; Manganiello, G.; Lorito, M. Trichoderma-based products and their widespread use in agriculture. Open Mycol. J. 2014, 8, 71–126. [Google Scholar] [CrossRef]
- Lamichhane, J.R.; Dachbrodt-Saaydeh, S.; Kudsk, P.; Messéan, A. Toward a reduced reliance on conventional pesticides in European agriculture. Am. Phytopathol. Soc. 2016, 100, 10–24. [Google Scholar] [CrossRef]
- Gramaje, D.; Urbez-Torres, J.R.; Sosnowski, M.R. Managing grapevine trunk diseases with respect to etiology and epidemiology: Current strategies and future prospects. Plant Dis. 2018, 102. [Google Scholar] [CrossRef]
- Pertot, I.; Giovannini, O.; Benanchi, M.; Caffi, T.; Rossi, V.; Mugnai, L. Combining biocontrol agents with different mechanisms of action in a strategy to control Botrytis cinerea on grapevine. Crop Prot. 2017, 97, 85–93. [Google Scholar] [CrossRef]
- Perazzolli, M.; Roatti, B.; Bozza, E.; Pertot, I. Trichoderma harzianum T39 induces resistance against downy mildew by priming for defense without costs for grapevine. Biol. Control 2011, 58, 74–82. [Google Scholar] [CrossRef]
- Mondello, V.; Songy, A.; Battiston, E.; Pinto, C.; Coppin, C.; Trotel-Aziz, P.; Clément, C.; Mugnai, L.; Fontaine, F. Grapevine trunk diseases: A review of fifteen years of trials for their control with chemicals and biocontrol agents. Plant Dis. 2018, 102, 1189–1217. [Google Scholar] [CrossRef]
- Bertsch, C.; Ramírez-Suero, M.; Magnin-Robert, M.; Larignon, P.; Chong, J.; Abou-Mansour, E.; Spagnolo, A.; Clément, C.; Fontaine, F. Grapevine trunk diseases: Complex and still poorly understood. Plant Pathol. 2013, 62, 243–265. [Google Scholar] [CrossRef]
- Roblin, G.; Luini, E.; Fleurat-Lessard, P.; Larignon, P.; Berjeaud, J.M. Towards a preventive and/or curative treatment of esca in grapevine trunk disease: General basis in the elaboration of treatments to control plant pathogen attacks. Crop Prot. 2019, 116, 156–169. [Google Scholar] [CrossRef]
- Berbegal, M.; Ramón-Albalat, A.; León, M.; Armengol, J. Evaluation of long-term protection from nursery to vineyard provided by Trichoderma atroviride SC1 against fungal grapevine trunk pathogens. Pest Manag. Sci. 2020, 76, 967–977. [Google Scholar] [CrossRef]
- Reggori, F.; Aloi, C.; Baleani, M.; Benanchi, M.; Bigot, G.; Bortolotti, P.; Bossio, D.; Cotromino, M.; Di Marco, S.; Faccini, F.; et al. Remedier(Trichoderma asperellum and Trichoderma gamsii): A new opportunity to control the esca disease complex. Four-year results of field trials in Italy. Phytopathol. Mediterr. 2014, 2, 363–372. [Google Scholar]
- Mutawila, C.; Halleen, F.; Mostert, L. Optimisation of time of application of Trichoderma biocontrol agents for protection of grapevine pruning wounds. Aust. J. Grape Wine Res. 2016, 22, 279–287. [Google Scholar] [CrossRef]
- Martínez-Diz, M.D.P.; Díaz-Losada, E.; Andrés-Sodupe, M.; Bujanda, R.; Maldonado-González, M.M.; Ojeda, S.; Yacoub, A.; Rey, P.; Gramaje, D. Field evaluation of biocontrol agents against black-foot and Petri diseases of grapevine. Pest Manag. Sci. 2020. [Google Scholar] [CrossRef]
- Berlanas, C.; Andrés-Sodupe, M.; López-Manzanares, B.; Maldonado-González, M.M.; Gramaje, D. Effect of white mustard cover crop residue, soil chemical fumigation and Trichoderma spp. root treatment on black-foot disease control in grapevine. Pest Manag. Sci. 2018. [Google Scholar] [CrossRef]
- Mayo, S.; Gutiérrez, S.; Malmierca, M.G.; Lorenzana, A.; Campelo, M.P.; Hermosa, R.; Casquero, P.A. Influence of Rhizoctonia solani and Trichoderma spp. in growth of bean (Phaseolus vulgaris L.) and in the induction of plant defense-related genes. Front. Plant Sci. 2015, 6, 1–11. [Google Scholar] [CrossRef]
- Álvarez-Pérez, J.M.; González-García, S.; Cobos, R.; Olego, M.Á.; Ibañez, A.; Díez-Galán, A.; Garzón-Jimeno, E.; Coque, J.J.R. Use of endophytic and rhizosphere actinobacteria from grapevine plants to reduce nursery fungal graft infections that lead to young grapevine decline. Appl. Environ. Microbiol. 2017, 83, 1–16. [Google Scholar] [CrossRef] [PubMed]
- Karimi, K.; Babai Ahari, A.; Arzanlou, M.; Amini, J.; Pertot, I. Comparison of indigenous Trichoderma spp. strains to a foreign commercial strain in terms of biocontrol efficacy against Colletotrichum nymphaeae and related biological features. J. Plant Dis. Prot. 2017, 124, 453–466. [Google Scholar] [CrossRef]
- Donnison, L.M.; Griffith, G.S.; Hedger, J.; Hobbs, P.J.; Bardgett, R.D. Management influences on soil microbial communities and their function in botanically diverse haymeadows of northern England and Wales. Soil Biol. Biochem. 2000, 32, 253–263. [Google Scholar] [CrossRef]
- Hernandez, M.M.; Menéndez, C.M. Influence of seasonality and management practices on diversity and composition of fungal communities in vineyard soils. Appl. Soil Ecol. 2019, 135, 113–119. [Google Scholar] [CrossRef]
- Vukicevich, E.; Thomas Lowery, D.; Bennett, J.A.; Hart, M. Influence of groundcover vegetation, soil physicochemical properties, and irrigation practices on soil fungi in semi-arid vineyards. Front. Ecol. Evol. 2019, 7, 1–10. [Google Scholar] [CrossRef]
- López-Piñeiro, A.; Muñoz, A.; Zamora, E.; Ramírez, M. Influence of the management regime and phenological state of the vines on the physicochemical properties and the seasonal fluctuations of the microorganisms in a vineyard soil under semi-arid conditions. Soil Tillage Res. 2013, 126, 119–126. [Google Scholar] [CrossRef]
- Pancher, M.; Ceol, M.; Corneo, P.E.; Longa, C.M.O.; Yousaf, S.; Pertot, I.; Campisano, A. Fungal endophytic communities in grapevines (Vitis vinifera L.) Respond to crop management. Appl. Environ. Microbiol. 2012, 78, 4308–4317. [Google Scholar] [CrossRef] [PubMed]
- Ferrigo, D.; Causin, R.; Raiola, A. Effect of potential biocontrol agents selected among grapevine endophytes and commercial products on crown gall disease. BioControl 2017, 62, 821–833. [Google Scholar] [CrossRef]
- Gramaje, D.; Mostert, L.; Groenewald, J.Z.; Crous, P.W. Phaeoacremonium: From esca disease to phaeohyphomycosis. Fungal Biol. 2015, 119, 759–783. [Google Scholar] [CrossRef]
- Pierron, R.; Gorfer, M.; Berger, H.; Jacques, A.; Sessitsch, A.; Strauss, J.; Compant, S. Deciphering the niches of colonisation of Vitis vinifera L. by the Esca-associated fungus Phaeoacremonium aleophilum using a gfp marked strain and cutting systems. PLoS ONE 2015, 10, e0126851. [Google Scholar] [CrossRef]
- Crous, P.W.; Gams, W.; Wingfield, M.J.; Van Wyk, P.S. Phaeoacremonium gen. nov. associated with with and decline diseases of woody hosts and human infections. Mycologia 1996, 88, 786–796. [Google Scholar] [CrossRef]
- Larignon, P.; Dubos, B. Preliminary studies on the biology of Phaeoacremonium. Phytopathol. Mediterr. 2000, 39, 184–189. [Google Scholar] [CrossRef]
- Agustí-Brisach, C.; Gramaje, D.; García-Jiménez, J.; Armengol, J. Detection of black-foot and Petri disease pathogens in soils of grapevine nurseries and vineyards using bait plants. Plant Soil 2013, 364, 5–13. [Google Scholar] [CrossRef]
- Roberti, R.; Osti, F.; Innocenti, G.; Rombolà, A.D.; Di Marco, S. An environmentally sustainable approach for the management of Phaeoacremonium minimum, the main agent of wood diseases in Actinidia deliciosa. Eur. J. Plant Pathol. 2017, 148, 151–162. [Google Scholar] [CrossRef]
- Rifai, M.A. A revision of the genus Trichoderma. Mycol. Pap. 1969, 116, 1–56. [Google Scholar]
- White, T.J.; Bruns, T.; Lee, S.; Taylor, J.W. Amplification and direct sequencing of fungal ribosomal RNA genes for phylogenetics. In PCR Protocols: A Guide to Methods and Applications; Academic Press: San Diego, CA, USA, 1990; pp. 315–322. [Google Scholar]
- Zhang, Z.; Schwartz, S.; Wagner, L.; Miller, W. A greedy algorithm for aligning DNA sequences. J. Comput. Biol. 2000, 7, 203–214. [Google Scholar] [CrossRef]
- Martín, L.; Martín, M.T. Characterization of fungicide resistant isolates of Phaeoacremonium aleophilum infecting grapevines in Spain. Crop Prot. 2013, 52, 141–150. [Google Scholar] [CrossRef]
- R Development Core Team. R: A Language and Environment for Statistical Computing Disponible En. Available online: http://www.r-project.org/ (accessed on 3 January 2021).
- Pertot, I.; Prodorutti, D.; Colombini, A.; Pasini, L. Trichoderma atroviride SC1 prevents Phaeomoniella chlamydospora and Phaeoacremonium aleophilum infection of grapevine plants during the grafting process in nurseries. BioControl 2016, 61, 257–267. [Google Scholar] [CrossRef]
- Bruez, E.; Vallance, J.; Gerbore, J.; Lecomte, P.; Da Costa, J.P.; Guerin-Dubrana, L.; Rey, P. Analyses of the temporal dynamics of fungal communities colonizing the healthy wood tissues of esca leaf-symptomatic and asymptomatic vines. PLoS ONE 2014, 9, e95928. [Google Scholar] [CrossRef]
- Bruez, E.; Haidar, R.; Alou, M.T.; Vallance, J.; Bertsch, C.; Mazet, F.; Fermaud, M.; Deschamps, A.; Guerin-Dubrana, L.; Compant, S.; et al. Bacteria in a wood fungal disease: Characterization of bacterial communities in wood tissues of esca-foliar symptomatic and asymptomatic grapevines. Front. Microbiol. 2015, 6, 1–12. [Google Scholar] [CrossRef]
- Carvalho, F.P. Agriculture, pesticides, food security and food safety. Environ. Sci. Policy 2006, 9, 685–692. [Google Scholar] [CrossRef]
- Jayawardena, R.S.; Purahong, W.; Zhang, W.; Wubet, T.; Li, X.H.; Liu, M.; Zhao, W.; Hyde, K.D.; Liu, J.H.; Yan, J. Biodiversity of fungi on Vitis vinifera L. revealed by traditional and high-resolution culture-independent approaches. Fungal Divers. 2018, 90, 1–84. [Google Scholar] [CrossRef]
- González, V.; Tello, M.L. The endophytic mycota associated with Vitis vinifera in central Spain. Fungal Divers. 2011, 47, 29–42. [Google Scholar] [CrossRef]
- Hjeljord, L.; Tronsmo, A. Trichoderma and Gliocladium in biological control: An overview. In Trichoderma and Gliocladium; Harman, G.E., Kubicek, C.P., Eds.; Taylor and Francis: London, UK, 1998; Volume 2, pp. 131–151. [Google Scholar]
- Mukherjee, P.K.; Horwitz, B.A.; Herrera-Estrella, A.; Schmoll, M.; Kenerley, C.M. Trichoderma research in the genome era. Annu. Rev. Phytopathol. 2013, 51, 105–129. [Google Scholar] [CrossRef] [PubMed]
- van Jaarsveld, W.J.; Halleen, F.; Bester, M.C.; Pierron, R.J.G.; Stempien, E.; Mostert, L. Investigation of Trichoderma species colonization of nursery grapevines for improved management of black foot disease. Pest Manag. Sci. 2021, 77, 397–405. [Google Scholar] [CrossRef]
- Kotze, C.; Van Niekerk, J.; Mostert, L.; Halleen, F.; Fourie, P.; Niekerk, J.V.A.N.; Mostert, L.; Halleen, F.; Fourie, P. Evaluation of biocontrol agents for grapevine pruning wound protection against trunk pathogen infection. Phytopathol. Mediterr. 2011, 50, 247–263. [Google Scholar] [CrossRef]
- Ruano-Rosa, D.; Del Moral-Navarrete, L.; Lopez-Herrera, C.J. Selection of Trichoderma spp. isolates antagonistic to Rosellinia necatrix. Span. J. Agric. Res. 2010, 8, 1084–1097. [Google Scholar] [CrossRef]
- Marraschi, R.; Ferreira, A.B.M.; da Silva Bueno, R.N.; Leite, J.A.B.P.; Lucon, C.M.M.; Harakava, R.; Leite, L.G.; Padovani, C.R.; Bueno, C.J. A protocol for selection of Trichoderma spp. to protect grapevine pruning wounds against Lasiodiplodia theobromae. Braz. J. Microbiol. 2019, 50, 213–221. [Google Scholar] [CrossRef]
- Carro-Huerga, G.; Compant, S.; Gorfer, M.; Cardoza, R.E.; Schmoll, M.; Gutiérrez, S.; Casquero, P.A. Colonization of Vitis vinifera L. by the endophyte Trichoderma sp. strain T154: Biocontrol activity against Phaeoacremonium minimum. Front. Plant Sci. 2020, 11, 1–15. [Google Scholar] [CrossRef]
- John, S.; Wicks, T.J.; Hunt, J.S.; Scott, E.S. Colonisation of grapevine wood by Trichoderma harzianum and Eutypa lata. Aust. J. Grape Wine Res. 2008, 14, 18–24. [Google Scholar] [CrossRef]
- Halleen, F.; Fourie, P.H.; Lombard, P.J. Protection of grapevine pruning wounds against Eutypa lata by biological and chemical methods. S. Afr. J. Enol. Vitic. 2010, 31, 125–132. [Google Scholar] [CrossRef]
- Pascale, A.; Vinale, F.; Manganiello, G.; Nigro, M.; Lanzuise, S.; Ruocco, M.; Marra, R.; Lombardi, N.; Woo, S.L.; Lorito, M. Trichoderma and its secondary metabolites improve yield and quality of grapes. Crop Prot. 2017, 92, 176–181. [Google Scholar] [CrossRef]
- Ruano Rosa, D.; López Herrera, C.J. Evaluation of Trichoderma spp. as biocontrol agents against avocado white root rot. Biol. Control 2009, 51, 66–71. [Google Scholar] [CrossRef]
- Cardoza, R.; Hermosa, R.; Vizcaíno, J.; Sanz, L.; Monte, E.; Gutiérrez, S. Secondary metabolites produced by Trichoderma and their importance in the biocontrol process. Res. Signpost Indian 2005, 661, 207. [Google Scholar]
- Mutawila, C.; Vinale, F.; Halleen, F.; Lorito, M.; Mostert, L. Isolation, production and in vitro effects of the major secondary metabolite produced by Trichoderma species used for the control of grapevine trunk diseases. Plant Pathol. 2015, 65, 104–113. [Google Scholar] [CrossRef]
- Keswani, C.; Singh, H.B.; Hermosa, R.; García-Estrada, C.; Caradus, J.; He, Y.W.; Mezaache-Aichour, S.; Glare, T.R.; Borriss, R.; Vinale, F.; et al. Antimicrobial secondary metabolites from agriculturally important fungi as next biocontrol agents. Appl. Microbiol. Biotechnol. 2019, 103, 9287–9303. [Google Scholar] [CrossRef]
- Rodríguez-González, Á.; Peláez, H.J.; Mayo, S.; González-López, O.; Casquero, P.A. Biometric traits of Xylotrechus arvicola adults from laboratory and grape fields. Vitis-J. Grapevine Res. 2016, 55, 73–78. [Google Scholar] [CrossRef]
- Rodríguez-González, Á.; Carro-Huerga, G.; Mayo-Prieto, S.; Lorenzana, A.; Gutiérrez, S.; Peláez, H.J.; Casquero, P.A. Investigations of Trichoderma spp. and Beauveria bassiana as biological control agent for Xylotrechus arvicola, a major insect pest in Spanish vineyards. J. Econ. Entomol. 2018, 1–7. [Google Scholar] [CrossRef]
- Bruez, E.; Baumgartner, K.; Bastien, S.; Travadon, R.; Guérin-Dubrana, L.; Rey, P. Various fungal communities colonise the functional wood tissues of old grapevines externally free from grapevine trunk disease symptoms. Aust. J. Grape Wine Res. 2016, 288–295. [Google Scholar] [CrossRef]
- Roberti, R.; Badiali, F.; Pisi, A.; Veronesi, A.; Pancaldi, D.; Cesari, A. Sensitivity of Clonostachys rosea and Trichoderma spp. as potential biocontrol agents to pesticides. J. Phytopathol. 2006, 154, 100–109. [Google Scholar] [CrossRef]
- Rusjan, D.; Strlič, M.; Pucko, D.; Korošec-Koruza, Z. Copper accumulation regarding the soil characteristics in Sub-Mediterranean vineyards of Slovenia. Geoderma 2007, 141, 111–118. [Google Scholar] [CrossRef]
- Pertot, I.; Caffi, T.; Rossi, V.; Mugnai, L.; Hoffmann, C.; Grando, M.S.; Gary, C.; Lafond, D.; Duso, C.; Thiery, D.; et al. A critical review of plant protection tools for reducing pesticide use on grapevine and new perspectives for the implementation of IPM in viticulture. Crop Prot. 2017, 97, 70–84. [Google Scholar] [CrossRef]

| Site | Location | Vine Varieties | Dates Sampled | Year Vineyard Stablished | 
|---|---|---|---|---|
| PDO LEÓN | ||||
| 1 | La Antigua, Castilla y León | Prieto Picudo | January 2017 | 1934 | 
| 2 | La Bañeza, Castilla y León | Tempranillo | January 2017 | 2001 | 
| 3 | Gordoncillo, Castilla y León | Albarín blanco | February 2017 | 2006 | 
| 4 | Gordoncillo, Castilla y León | Prieto Picudo | February 2017 | 1997 | 
| PDO TORO | ||||
| 5 | El Pego, Castilla y León | Tempranillo | February 2017 | 1926 | 
| PDO BIERZO | ||||
| 6 | Cacabelos, Castilla y León | Mencía | January 2017 | 1995 | 
| 7 | Cacabelos, Castilla y León | Godello | January 2017 | 2011 | 
| 8 | Cacabelos, Castilla y León | Godello | January 2017 | 1937 | 
| PDO RIBERA DEL DUERO | ||||
| 9 | Peñafiel, Castilla y León | Tempranillo | February 2017 | 2001 | 
| 10 | Peñafiel, Castilla y León | Cabernet Sauvignon | February 2017 | 2008 | 
| Site | Media Number of Fungicides Spraying per Campaign | Sulphur | Cooper | Synthetic Fungicides | 
|---|---|---|---|---|
| PDO LEÓN | ||||
| 1 | 0 | no | no | no | 
| 2 | 5.2 | yes | yes | yes | 
| 3 | 4 | yes | no | yes | 
| 4 | 4 | yes | no | yes | 
| PDO TORO | ||||
| 5 | 3 | yes | yes | no | 
| PDO BIERZO | ||||
| 6 | 5.9 | yes | yes | yes | 
| 7 | 5.1 | yes | yes | yes | 
| 8 | 5.9 | yes | yes | yes | 
| PDO RIBERA DEL DUERO | ||||
| 9 | 5 | yes | yes | yes | 
| 10 | 5 | yes | yes | yes | 
| Isolate | Species | Accesion Number | Site | 
|---|---|---|---|
| PDO LEÓN | |||
| T72 | Trichoderma gamsii | 1 | |
| T73 | Trichoderma gamsii | 1 | |
| T74 | Trichoderma koningiopsis | 1 | |
| T75 | Trichoderma koningiopsis | 1 | |
| T76 | Trichoderma spp. | 1 | |
| T77 | Trichoderma koningiopsis | 1 | |
| T78 | Trichoderma gamsii | 1 | |
| T138 | Trichoderma spp. | 2 | |
| T139 | Trichoderma gamsii | 2 | |
| T100 | Trichoderma gamsii | 3 | |
| T105 | Trichoderma gamsii | 4 | |
| T106 | Trichoderma spp. | 4 | |
| PDO TORO | |||
| T79 | Trichoderma spp. | 5 | |
| T80 | Trichoderma koningiopsis | 5 | |
| T81 | Trichoderma harzianum | 5 | |
| T82 | Trichoderma gamsii | 5 | |
| T84 | Trichoderma koningiopsis | 5 | |
| T85 | Trichoderma gamsii | 5 | |
| PDO BIERZO | |||
| T136 | Trichoderma gamsii | 6 | |
| T137 | Trichoderma citrinoviride | 6 | |
| T135 | Trichoderma gamsii | 8 | |
| T170 | Trichoderma gamsii | 8 | |
| T171 | Trichoderma gamsii | 8 | |
| PDO RIBERA DEL DUERO | |||
| T154 | Trichoderma spp. | 9 | |
| T151 | Trichoderma atroviride | 10 | |
| Isolate | Dual Culture (%GI) | Sporulation on Plate | Sporulation on Pathogen | Production of Yellow Pigment | Origin | 
|---|---|---|---|---|---|
| DPO LEÓN | |||||
| T72 | 20.42 abc | 0.33 | 0.00 | 0.00 | 1 | 
| T73 | 14.62 bcde | 0.50 | 0.00 | 0.00 | 1 | 
| T74 | 20.42 abc | 0.83 | 0.17 | 0.00 | 1 | 
| T75 * | 19.51 abcd | 0.92 * | 0.67 * | 0.00 | 1 | 
| T76 | 11.66 cdefg | 0.33 | 0.00 | 0.00 | 1 | 
| T77 | 22.02 ab | 0.75 | 0.17 | 0.00 | 1 | 
| T78 | 22.92 ab | 0.75 | 0.00 | 0.00 | 1 | 
| T138 | 4.04 g | 0.33 | 0.00 | 0.00 | 2 | 
| T139 | 9.25 efg | 0.33 | 0.00 | 0.00 | 2 | 
| T100 | −5.19 h | 0.08 | 0.00 | 0.00 | 3 | 
| T105 | 23.77 a | 0.42 | 0.00 | 0.00 | 4 | 
| T106 | 17.30 abcde | 0.25 | 0.00 | 0.67 * | 4 | 
| DPO TORO | |||||
| T79 * | 20.30 abc | 1.00 * | 0.67 * | 0.33 | 5 | 
| T80 | 22.40 ab | 0.42 | 0.67 | 0.00 | 5 | 
| T81 | 12.36 cdefg | 0.75 | 0.50 | 0.08 | 5 | 
| T82 | 16.14 abcde | 0.58 | 0.00 | 0.00 | 5 | 
| T84 * | 17.84 abcde | 0.67 * | 0.67 * | 0.00 | 5 | 
| T85 | 15.33 abcde | 0.75 | 0.00 | 0.00 | 5 | 
| DPO BIERZO | |||||
| T136 | 13.15 cdef | 1.00 | 0.17 | 0.00 | 6 | 
| T137 | 12.69 cdefg | 1.00 | 0.00 | 0.00 | 6 | 
| T135 | 11.65 cdefg | 0.33 | 0.00 | 0.00 | 8 | 
| T170 | 10.93 defg | 0.33 | 0.00 | 0.00 | 8 | 
| T171 | 12.86 cdefg | 0.08 | 0.00 | 0.00 | 8 | 
| DPO RIBERA DEL DUERO | |||||
| T154 * | 20.38 abc | 1.00 * | 0.67 * | 0.00 | 9 | 
| T151 | 4.57 fg | 0.58 | 0.00 | 0.00 | 10 | 
| Combination of Management | Correlation | p Value | 
|---|---|---|
| Trichoderma plant abundance and Fungicides | −0.88382 | 0.00069 | 
| Trichoderma plant abundance and Age | 0.67559 | 0.03202 | 
| Fungicides and Age | −0.52270 | 0.1211 | 
| Publisher’s Note: MDPI stays neutral with regard to jurisdictional claims in published maps and institutional affiliations. | 
© 2021 by the authors. Licensee MDPI, Basel, Switzerland. This article is an open access article distributed under the terms and conditions of the Creative Commons Attribution (CC BY) license (http://creativecommons.org/licenses/by/4.0/).
Share and Cite
Carro-Huerga, G.; Mayo-Prieto, S.; Rodríguez-González, Á.; González-López, Ó.; Gutiérrez, S.; Casquero, P.A. Influence of Fungicide Application and Vine Age on Trichoderma Diversity as Source of Biological Control Agents. Agronomy 2021, 11, 446. https://doi.org/10.3390/agronomy11030446
Carro-Huerga G, Mayo-Prieto S, Rodríguez-González Á, González-López Ó, Gutiérrez S, Casquero PA. Influence of Fungicide Application and Vine Age on Trichoderma Diversity as Source of Biological Control Agents. Agronomy. 2021; 11(3):446. https://doi.org/10.3390/agronomy11030446
Chicago/Turabian StyleCarro-Huerga, Guzmán, Sara Mayo-Prieto, Álvaro Rodríguez-González, Óscar González-López, Santiago Gutiérrez, and Pedro A. Casquero. 2021. "Influence of Fungicide Application and Vine Age on Trichoderma Diversity as Source of Biological Control Agents" Agronomy 11, no. 3: 446. https://doi.org/10.3390/agronomy11030446
APA StyleCarro-Huerga, G., Mayo-Prieto, S., Rodríguez-González, Á., González-López, Ó., Gutiérrez, S., & Casquero, P. A. (2021). Influence of Fungicide Application and Vine Age on Trichoderma Diversity as Source of Biological Control Agents. Agronomy, 11(3), 446. https://doi.org/10.3390/agronomy11030446
 
         
                                                




 
       